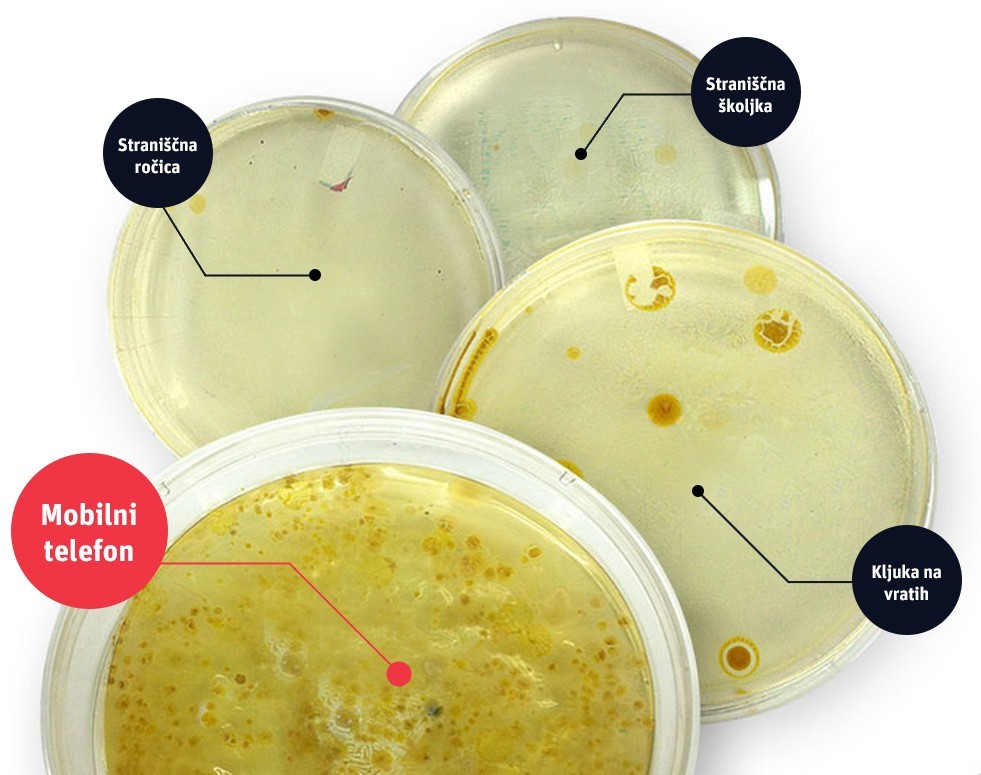
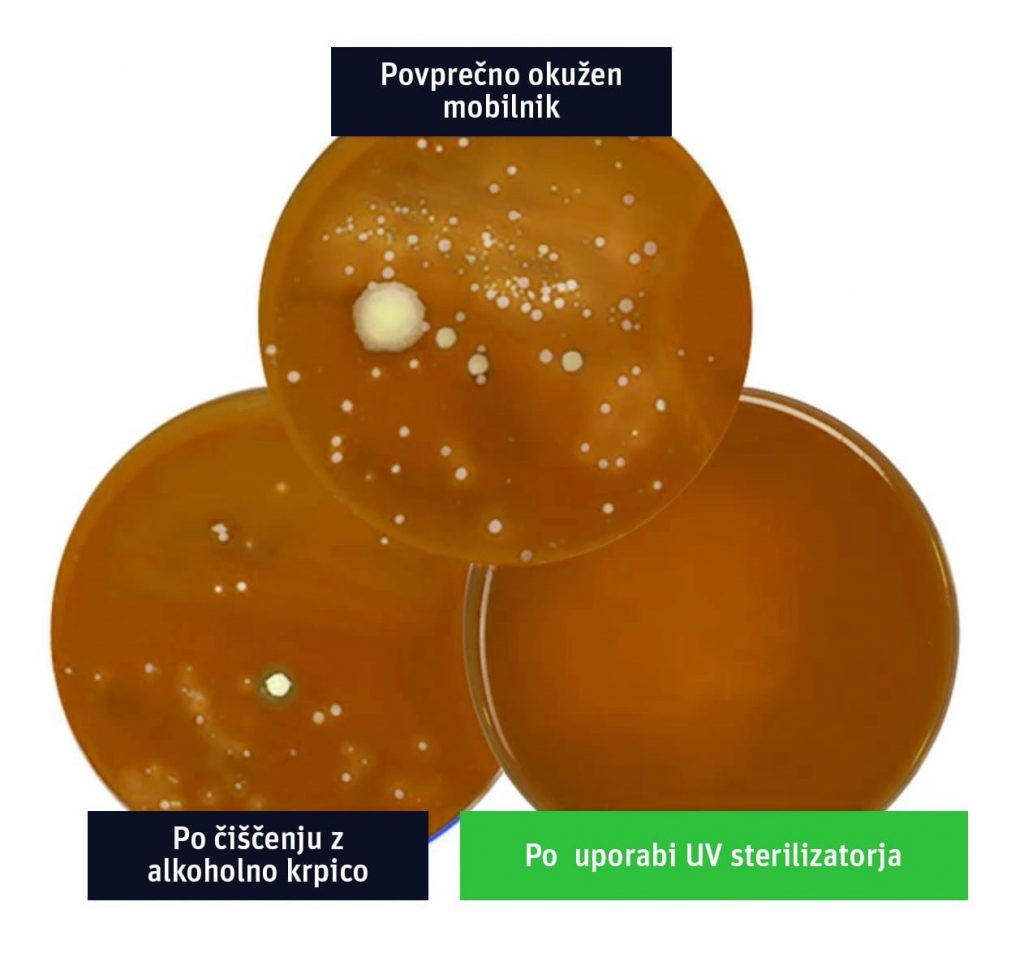

Ko govorimo o nevarnosti bakterij in virusov, verjetno najprej pomislite na ljudi, ki kašljajo in kihajo vse povprek, umazane straniščne školjke javnih stranišč, ali javne prevoze polne bacilov. Redko kdo se zaveda, da enega najbolj okuženih pripomočkov vsak dan prostovoljno prislanjamo na obraz.
Vaš pametni telefon predstavlja večjo grožnjo vašemu zdravju, kot si predstavljate. Z enim klicem lahko na svoj obraz spustite več 10.000 nevarnih bakterij. Koliko klicev opravite vsak dan?
Bodite pozorni na predmete, ki se jih pogosto dotikate!
Ker se veliko nalezljivih bolezni ne prenaša po zraku, pač pa kapljično, zaščita obraza ne predstavlja najučinkovitejše zaščite pred okužbo. Veliko bolj učinkovito je, če nevarnost uničimo, še preden ima možnost priti v bližino obraza.
“Bodite pozorni na predmete, ki se jih pogosto dotikate. Najpogosteje v rokah držimo svoje telefone, zato zaščita za obraz ni najpomembnejša zaščita,” poroča direktor zdravstvenih storitev singapurskega Ministrstva za zdravstvo, Kenneth Mak. Singapur je sicer znan kot primer najbolj ostrega, a zelo učinkovitega ukrepanja proti širitvi nalezljivih bolezni.
Namesto obrazne zaščite, kot poroča Mak, raje poskrbite za čist in razkužen telefon, vašo tretjo roko, ki spada med najbolj onesnažene predmete v vaši lasti.
Telefoni so z naskokom najbolj onesnažen predmet, ki ga uporabljamo vsak dan
Pametni telefoni nas spremljajo na vsakem koraku. Ob sebi ga imamo na javnem stranišču, na javnem prevozu, v fitnesu, centru mesta, restavracijah … Česar se dotaknemo z rokami, sčasoma pristane na telefonu in kasneje na obrazu. Roke po obisku stranišča temeljito umijemo. Kaj pa telefon?
Slika: Po vašem pametnem telefonu v tem trenutku pustoši kar 18 krat več bacilov kot na ročici za splakovanje na javnem moškem stranišču.
Pametni telefoni spadajo med najbolj onesnažene predmete, mi pa jih vsakodnevno prislanjamo k ušesom, očem, nosu in ustom. Raziskave so pokazale, da se na kvadratnem centimetru povprečnega pametnega telefona nahaja kar 4 tisoč nevarnih bakterij.
Morda pred tem niste niti pomislili, da tudi svoje najmlajše izpostavljate nevarnim boleznim vsakič, ko jim ponudite telefon, da se zamotijo.
Otroški vrtci so raj za prenos bacilov in virusnih obolenj – starši nemalokrat spustijo v vrtec nezdrave malčke, ki prenesejo bakterije na vašega otroka, ta pa na vaš telefon.
Kako z eno potezo najučinkoviteje zaščitite sebe in svoje bližnje (in ne uničite svojega telefona)?
Pozabite na čistilna sredstva. Proti bakterijam in virusom učinkujejo le alkoholne in druge jedke raztopine, ki bodo čez čas razjedle tudi vašo kožo in poseben premaz na vašem telefonu. Izogibajte se tudi čistil za kuhinjo, odstranjevalcev ličil, detergentov, mila za roke ter kisa.
Na srečo obstaja 100% učinkovit in varen način, ki ne poškoduje vašega telefona in v eni potezi uniči bakterije ter viruse.
Novost na trgu, ki zagotavlja najučinkovitejšo zaščito pred nevarnimi prenašalci bolezni na vašem telefonu, so posebni UV razkuževalniki. Med najbolj priznanimi na evropskem tržišču je Optishield® Sanitizer, v Združenih državah pa Phone Soap®.

Slika: Razkuževalnik s pomočjo UV žarkov telefon v 15 minutah medicinsko razkuži. Že po enem ciklu je čistejši kot takrat, ko ste ga prvič vzeli iz škatle.
UV razkuževalniki so se do zdaj uporabljali večinoma v bolnišnicah in medicinskih ustanovah, zdaj pa so na voljo tudi prve cenovno dostopnejše verzije, ki so primerne za domačo rabo.
Telefon je tako po 15 minutah sterilizacije veliko varnejši za uporabo, saj na njem ne prenašate desettisočev nevarnih bacilov, ki dnevno ogrožajo zdravje vas in vaših najbližjih.
Slika: Razkuževalniki s kratkovalovnim sevanjem UV-C žarkov razdrejo kemijsko sestavo virusov in bakterij, kar onemogoči njihovo delovanje in razmnoževanje.
Zakaj je Optishield® Sanitizer edina učinkovita izbira za čistočo vaših naprav in kje je še na voljo?
Optishield® Sanitizer v primerjavi s klasičnimi čistili in alkoholnimi krpicami:
● Trajno uniči preko 99.9% prenašalcev bolezni na vašem telefonu
● Je dolgoročno popolnoma varen za telefon
● Na telefonu ne pušča sledi kemikalij in je varen za vašo kožo
● Je enkratna investicija – prihranek na dolgi rok
● Ima 28-dnevno garancijo na zadovoljstvo ob nakupu
Optishield® Sanitizer pri nas trenutno še ni na voljo v vsakem supermarketu, možno pa ga je dobiti z varnim naročilom preko spleta.
Izdelek ni na voljo v fizičnih trgovinah in lekarnah, lahko pa ga po oddaji spletnega naročila prevzamete tudi osebno.
Glede na trenutno stanje s smrtonosnim COVID-19 “Koronavirusom” prodajalci poročajo, da se je število naročil, tako kot za zaščitne maske, znatno povečalo, zato ne morejo obljubiti, kako dolgo bodo razkuževalniki Optishield® Sanitizer še na voljo.

